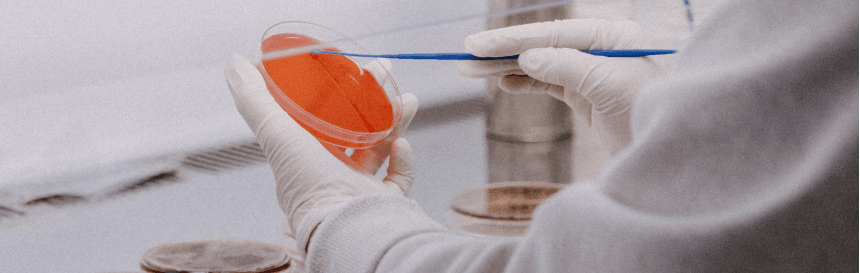

Funded by the Amgen Foundation and developed at Harvard University, LabXchange is a free, online platform for science learning that provides middle school, high school and university level teachers and students with access to personalized instruction, virtual lab experiences and networking opportunities across the global scientific community.
Launched in 2020, the LabXchange platform offers digital content from the world’s leading science organizations and enables users to remix, adapt and assign customized learning experiences. LabXchange curated library continues to grow with resources that cover multiple disciplines across the sciences and select content available in 19 languages.
LabXchange and the vetted resources in the content library are freely accessible to all.
LabXchange and the Amgen Foundation are on a mission to break down barriers and bring science education to everyone, everywhere. We believe that technology complements in-person learning and can create authentic opportunities for young people to learn and engage in science.
Every young person should feel that they belong in science and empowered to find careers that ignite their passions. LabXchange is designed to drive more inclusion in the scientific process and enable creative, team-based approaches to real-world problems.
As the founding and lead sponsor of LabXchange, we are proud to have successfully reached the goal of engaging 50 million learners and educators worldwide, making science education accessible across the globe. Help us reach the next 50 million! Share LabXchange with your network by using ready-to-go emails and messaging, targeted for different audiences, including parents and teachers.
Students, teachers, lifelong learners, parents and guardians can freely access all of the content on LabXchange. Click on the links below to explore content made possible by the Amgen Foundation.
These multilingual resources expose learners to fundamental concepts and lab techniques essential to the field of biotechnology, based on curriculum of the accomplished Amgen Biotech Experience program.
These resources on LabXchange guide learners through the steps involved in making a solution when in a research lab, from finding the recipe and doing calculations to putting the ingredients together.
A snapshot of LabXchange’s global impact with Amgen Foundation support
Explore science education resources available on LabXchange.
Join a growing community that’s reshaping the future of online science education.